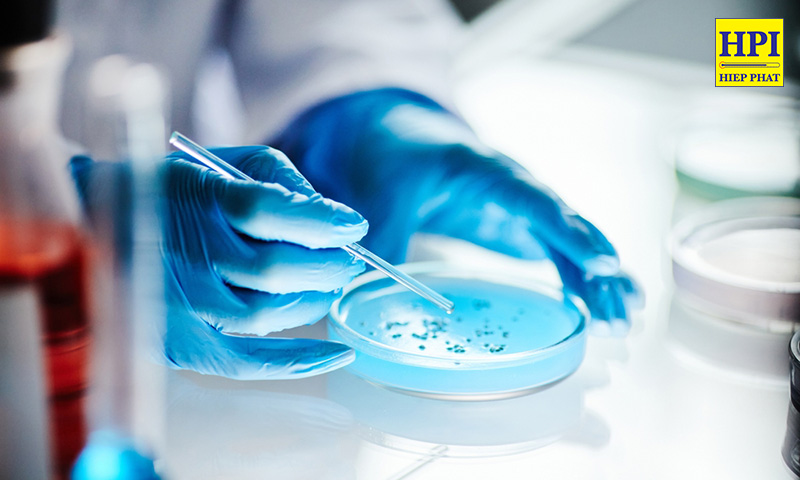
Phòng Thí Nghiệm Vi Sinh Là Gì? Danh Mục Thiết Bị Phòng Thí Nghiệm Vi Sinh

Phòng Thí Nghiệm Vi Sinh Là Gì? Danh Mục Thiết Bị Phòng Thí Nghiệm Vi Sinh
Hiện nay, phòng thí nghiệm vi sinh đang nhận được sự đầu tư mạnh mẽ trong nhiều lĩnh vực như y tế, thực phẩm, dược phẩm, và hơn thế nữa. Việc ứng dụng phòng thí nghiệm vi sinh không chỉ đảm bảo an toàn cho nhân viên mà còn mang lại hiệu quả nghiên cứu vượt trội. Trong bài viết này, Thiết bị Hiệp Phát sẽ chia sẻ những lưu ý quan trọng khi thiết kế phòng thí nghiệm vi sinh với các thiết bị phòng thí nghiệm hiện đại, đảm bảo chất lượng, an toàn và chi phí tối ưu.
Phòng thí nghiệm vi sinh là gì?
Phòng thí nghiệm vi sinh là không gian chuyên biệt được thiết kế để nghiên cứu, nuôi cấy và phân tích các đặc tính của vi sinh vật như vi khuẩn, virus, nấm men, và động vật nguyên sinh. Để đảm bảo an toàn cho nhân viên và môi trường, các phòng thí nghiệm vi sinh được bố trí kỹ lưỡng với hệ thống thiết bị phòng thí nghiệm vi sinh hiện đại, tuân thủ các tiêu chuẩn quốc tế như GLP (Good Laboratory Practices). Việc thiết kế và xây dựng cần được lên kế hoạch cẩn thận nhằm đảm bảo hiệu quả công việc và kiểm soát các rủi ro tiềm ẩn.
Tầm quan trọng của phòng thí nghiệm vi sinh
Phòng thí nghiệm vi sinh đóng vai trò quan trọng trong nhiều lĩnh vực như y tế, thực phẩm, dược phẩm, và nghiên cứu khoa học. Đây là nơi thực hiện các công việc như:
- Phân lập, nuôi cấy vi sinh, xác định đặc điểm vi sinh vật gây bệnh, hỗ trợ kiểm soát dịch bệnh và điều tra nguồn lây nhiễm.
- Thao tác với các mẫu chứa vi sinh vật như đất, nước, mô thực vật hoặc động vật.
- Xử lý mẫu chẩn đoán y tế và nghiên cứu DNA tái tổ hợp, thực vật hoặc động vật biến đổi gen.
- Thực hiện các thí nghiệm liên quan đến vi sinh vật trên động vật hoặc thực vật. Nhờ đó, phòng thí nghiệm vi sinh không chỉ đảm bảo an toàn mà còn mang lại hiệu quả nghiên cứu cao, đóng góp vào sự phát triển của khoa học và sức khỏe cộng đồng.

Tiêu chuẩn thiết kế phòng thí nghiệm vi sinh
Các phòng thí nghiệm vi sinh cần tuân thủ các tiêu chuẩn do các tổ chức uy tín như NIH, CDC, OSHA hoặc USDA APHIS đặt ra. Tuy nhiên, đối với các phòng thí nghiệm nội bộ, việc tham khảo các tiêu chuẩn này giúp tối ưu hóa thiết kế mà không nhất thiết phải đạt chứng nhận. Thiết bị phòng thí nghiệm vi sinh cần được lựa chọn kỹ lưỡng để đáp ứng yêu cầu kỹ thuật và an toàn.
Các khu vực chức năng trong phòng thí nghiệm vi sinh
Để tối ưu hóa hiệu suất, một phòng thí nghiệm vi sinh thường được chia thành các khu vực chuyên biệt, bao gồm:
- Khu vực nhận và bảo quản mẫu: Lưu trữ mẫu ở điều kiện thích hợp, chuẩn bị mẫu trước khi nuôi cấy.
- Khu vực pha môi trường và chuẩn bị mẫu: Lưu trữ và chuẩn bị môi trường nuôi cấy vi sinh vật.
- Khu vực hấp môi trường: Khử trùng môi trường nuôi cấy trước và sau khi sử dụng để đảm bảo an toàn.
- Khu vực cấy mẫu: Trang bị các thiết bị phòng thí nghiệm vi sinh chuyên dụng để thực hiện quá trình cấy mẫu.
- Khu vực cấy chuyển: Dành cho các xét nghiệm sinh hóa để xác định đặc tính vi sinh vật.
- Khu vực ủ mẫu: Duy trì nhiệt độ phù hợp để vi sinh vật phát triển.
- Khu vực hấp thủy môi trường và rửa dụng cụ: Khử trùng môi trường nuôi cấy trước và sau khi sử dụng để đảm bảo an toàn. Đồng thời làm sạch và sắp xếp các dụng cụ thí nghiệm.
Yêu cầu nhiệt độ đối với thiết bị trong phòng thí nghiệm vi sinh
Nhiệt độ thiết bị trong các phòng thí nghiệm vi sinh thường được duy trì ở mức nhiệt độ phòng cho các khu vực thao tác và pha môi trường.
Riêng khu vực bảo quản mẫu yêu cầu thiết bị bảo quản mẫu vi sinh có khả năng duy trì nhiệt độ từ 80°C đến -86°C để đảm bảo chất lượng mẫu. Đối với khu vực ủ mẫu, các thiết bị cần cung cấp nhiệt độ tối ưu để vi sinh vật phát triển hiệu quả.
Danh mục thiết bị phòng thí nghiệm vi sinh
Nhóm thiết bị chuyên dụng cho phòng vi sinh
Thiết bị phòng thí nghiệm vi sinh bao gồm thiết bị chuyên dụng như tủ an toàn sinh học, nồi hấp tiệt trùng, tủ ấm, kính hiển vi, máy đo pH, máy đo vòng vô khuẩn, máy đếm khuẩn lạc,… để đảm bảo môi trường làm việc an toàn và chính xác. Dưới đây là danh mục thiết bị phòng vi sinh phổ biến:
Tủ an toàn sinh học
Luồng không khí của Tủ an toàn sinh học (ATSH – Biosafety Cabinet) bao gồm một rào chắn ngăn chặn sự thoát ra ngẫu nhiên của các mối nguy hiểm sinh học khỏi khu vực làm việc của tủ. Nó cũng có luồng khí thổi xuống giúp loại bỏ các chất gây ô nhiễm khỏi khu vực làm việc, cung cấp khu vực vô trùng cho các mẫu.
Tủ ATSH là thiết bị kiểm soát kỹ thuật cơ bản, giúp bảo vệ người dùng, mẫu và môi trường chống lại các mối nguy hiếm sinh học.

Nồi hấp tiệt trùng
Nồi hấp tiệt trùng (Autoclave) là thiết bị tiệt trùng bằng hơi nước bão hòa, dùng để khử trùng những vật như dụng cụ phẫu thuật, thiết bị, dụng cụ y tế, hay các vật dụng trong phòng thí nghiệm.

Nguyên lý hoạt động của nồi hấp tiệt trùng: khi gia nhiệt, nồi hấp sẽ đóng kín các van và tạo áp suất cao trong buồng hấp, làm thay đổi nhiệt độ sôi và bay hơi của nước (thông thường nước sôi và bốc hơi ở 100°C) lên nhiệt độ cài đặt (thường sẽ là 121°C), khi đó sẽ tạo ra hơi nước bão hòa, ngưng tụ trong buồng hấp sẽ giải phóng năng lượng (2202 kJ/kg) giúp tiệt trùng, tiêu diệt vi sinh vật.
Theo nghiên cứu, tiệt trùng tại nhiệt độ từ 115°C đến 135°C (thường là khoảng 121°C), với mức áp suất dư từ 0,5 đến 2 bar, trong khoảng thời gian từ 15 – 20 phút, các vi khuẩn và vi sinh vật sẽ bị tiêu diệt hoàn toàn bởi những sự tác động từ hơi nước bão hòa dưới điều kiện áp suất cao.
Quý khách hàng có thể tham khảo thêm các dòngThiết Bị Tự Ghi Nhiệt Độ Trong Tiệt Trùng Tecnosoft SterilDisk

Tủ ấm
Tủ ấm (Incubator) là thiết bị duy trì độ ổn định (thường là khoảng 15°C đến 70°C) và phân bổ đồng đều để ủ môi trường nuôi cấy vi sinh vật. Một số tủ ấm chuyên dụng có kiểm soát CO2 và độ ẩm cho nuôi cấy tế bào.
Ứng dụng của tủ ấm trong phòng vi sinh:
- Ủ mẫu vi sinh (vi khuẩn, nấm men) ở nhiệt độ thích hợp để chúng phát triển
- Bảo quản môi trường vi sinh 15°C đến 25°C, trừ khi có quy định khác

Kính hiển vi
Kính Hiển Vi 3 Mắt Kruss MBL4000-T Series là kính hiển vi ánh sáng truyền qua, được thiết kế để kiểm tra các chế phẩm/mẫu/vật thể trên lam kính. Kính hiển vi thuộc loại kính hiển vi phức hợp. Những kính hiển vi này có thể phóng đại vật thể theo hai giai đoạn, thông qua vật kính và thị kính. Các thiết bị được trang bị nhiều vật kính phẳng tiêu sắc ở các mức phóng đại khác nhau từ 4X – 100X.

Máy đo đường kính vòng vô khuẩn
Máy Đo Vòng Vô Khuẩn IUL Haloes Caliper giúp thực hiện việc đo đạc này một cách đơn giản và chính xác, đồng thời tránh được các lỗi sai trong việc đọc kết quả. Các phòng thí nghiệm dược phẩm và y tế lâm sàng cần đo vòng vô khuẩn đều cần đến thiết bị này. Đo vòng vô khuẩn bằng cách dùng tay quay bánh xe. Đây là thiết bị thiết yếu trong các thử nghiệm độ nhạy kháng sinh và kiểm tra hoạt lực lực của kháng sinh.

Máy đo pH
Máy đo độ pH là thiết bị được sử dụng để xác định độ pH hay còn gọi là độ axit bazo, có thể thực hiện các phép đo chính xác đến ±0,1 đơn vị pH.
Ứng dụng: Đo độ pH của môi trường nuôi cấy vi sinh vật. Việc kiểm soát độ pH là rất quan trọng vì nó ảnh hưởng đến sự phát triển, sinh trưởng và hoạt động của vi sinh vật.

Máy đếm khuẩn lạc
Máy Đếm Khuẩn Lạc Tự Động IUL SphereFlash đáp ứng tất cả các yêu cầu cho các phòng kiểm nghiệm vi sinh hiện đại.
Với phần mềm Colony Lite, thiết bị có thể đếm khuẩn lạc một cách đơn giản và đáng tin cậy nhờ phần mềm đẳng cấp thế giới và tích hợp hệ thống chiếu sáng đã được cấp bằng sáng chế.
Đối với các yêu cầu cao cấp hơn, phần mềm có thể được nâng cấp lên Colonies PRO để mở rộng tính năng, ví dụ như: Cài đặt phân quyền người dùng, Kết nối LIMS, Bảng tính, Quét mã vạch, Tạo báo cáo, Audit Trail, hoặc đáp ứng CFR21 Part 11.

Nhóm thiết bị cơ bản
Bên cạnh đó, danh mục thiết bị phòng thí nghiệm vi sinh còn bao gồm một số thiết bị cơ bản khác:
Tủ sấy phòng thí nghiệm
Tủ sấy (Drying Oven) là thiết bị dùng để tạo và duy trì nhiệt độ cao (50°C đến 250°C). Có 2 loại tủ sấy phổ biến là Tủ sây đối lưu tự nhiên và tủ sấy đối lưu cưỡng bức.
Tủ sấy đối lưu tự nhiên
Dựa và sự truyền nhiệt từ vùng gia nhiệt tới không khí trong tủ và sự chuyển động dòng nhiệt nhờ chênh lệch nhiệt độ để sấy khô các vật liệu sấy -> Thời gian gia nhiệt của tủ lâu
Phù hợp để tiêu diệt các vi sinh vật bằng nhiệt khô với các dụng cụ thí nghiệm bằng thủy tinh như đĩa petri, ống đong ở 160°C đến 180°C trong vòng 2 giờ.

Tủ sấy đối lưu cưỡng bức
Được trang bị thêm một chiếc quạt để giúp tạo nên dòng khí nóng đối lưu trong tủ sấy -> Dòng khí trong tủ được lưu thông ổn định và có khả năng trao đổi nhiệt nhanh hơn.
Được dùng trong các nghiên cứu khảo sát nhiệt độ sấy mẫu, cần độ chính xác cao. Bên cạnh đó, tủ sấy đối lưu cưỡng bức còn có thể được dùng trong các đơn vị sản xuất thực phẩm để khảo sát hạn sử dụng bằng phương pháp gia tốc nhiệt.

Tủ lạnh bảo quản mẫu
Tủ lạnh cần đạt độ ổn định ở nhiệt độ 2°C đến 8°C.
Ứng dụng: Bảo quản chủng vi sinh vật hay bảo quản mẫu

Bể điều nhiệt
Bể điều nhiêt (hay bể ổn nhiệt – Water Bath) giúp giữ cho nhiệt độ của mẫu hoặc dung dịch không đổi trong suốt quá trình thí nghiệm hoặc sản xuất. Bể ổn nhiệt được đổ đầy chất lỏng có hoặc không có nắp đậy để hạn chế sự bay hơi và có nhiều dung tích khác nhau, từ 10 lit đến 45 lit.
Ứng dụng: Ổn định dạng lỏng của môi trường có thạch sau hập tiệt trùng ở 45°C.

Tham khảo dòng bể điều nhiệt nóng Jeiotech BW3-G Series
Nhiệt ẩm kế và thiết bị theo dõi nhiệt độ
Nhiệt ẩm kế theo dõi nhiệt độ và độ ẩm phòng sạch.

Thiết bị theo dõi nhiệt độ theo dõi nhiệt độ tủ ấm, tủ sấy, tủ lạnh,…

Cân phân tích
Cân phân tích là loại cân điện tử có độ chính xác cao, sai số tối thiểu là 0,001g hoặc 1mg -> Được thiết kế để đo lường khối lượng và thực hiện các phân tích chất lượng phức tạp với mẫu và chất chuẩn trong phép thử hoạt lực kháng sinh.

Cân kỹ thuật
Cân kỹ thuật là loại cân điện tử cung cấp kết quả đo lường nhanh với sai số tối thiểu là 0,1g hoặc 10mg -> Để xác định khối lượng phần mẫu thử cần được kiểm tra, thành phần của môi trường nuôi cấy.

Và một số thiết bị khác như:
- Máy đốt que cấy bằng hồng ngoại
- Máy khuấy từ gia nhiệt

- Bể rửa siêu âm

- Máy lắc Vortex

- Máy lắc

- Máy ly tâm

Dụng cụ phòng vi sinh
Bên cạnh các thiết bị chuyên dụng, để phòng vi sinh có thể hoạt động tốt đáp ứng tiêu chuẩn được đưa ra, còn cần các nhóm dụng cụ như:
- Đĩa petri
- Bình nuôi cấy
- Bông không thấm nước
- Giấy báo, giấy bạc
- Túi đựng mẫu
- Các loại que cấy
- Đèn khử trùng
Công ty TNHH Thiết bị Hiệp Phát hiện đang là nhà phân phối tất cả các dòng thiết bị, dụng cụ phòng thí nghiệm vi sinh, từ các hãng sản xuất hàng đầu trên thế giới như ALP, Jeiotech, Mettler Toledo, Kruss,… Với hơn 18 năm kinh nghiệm hoạt động trong lĩnh vực phân phối thiết bị phòng thí nghiệm, Hiệp Phát tự tin mang đến cho quý khách hàng các dòng sản phẩm chính hãng, cao cấp, cùng dịch vụ đi kèm, dịch vụ hậu mãi hấp dẫn. Nếu quý khách hàng đang có nhu cầu tìm mua các thiết bị nhằm xây dựng danh mục thiết bị phòng thí nghiệm vi sinh, đừng ngần ngại liên hệ với Thiết bị Hiệp Phát qua Sđt: 0919.537.653 – Mr. Tú hoặc Email: sales5@thietbihiepphat.com để được hỗ trợ kịp thời.

Để lại thắc mắc, chúng tôi sẽ giải đáp ngay cho bạn



 VN
VN














